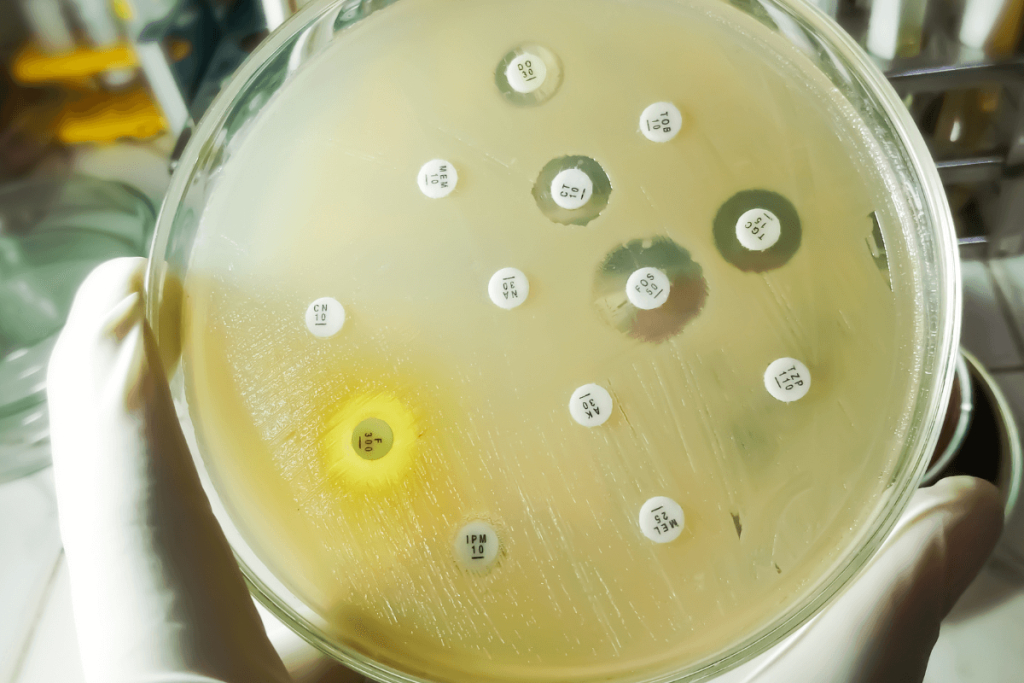

Integration of the PortionSize Ed App into SNAP-Ed for Improving Diet Quality Among Adolescents in Hawaii: A Randomized Pilot Study
Nutrients. 2025 Oct 1;17(19):3145. doi: 10.3390/nu17193145. ABSTRACT Background/Objectives: Coupling mobile health (mHealth) technology with community-based nutrition programs may enhance diet quality in adolescents. This pilot study evaluated the feasibility, acceptability, and preliminary efficacy of integrating PortionSize Ed (PSEd), an image-assisted dietary assessment and education app, into the six-week Hawaii Food and Lifeskills for Youth (HI-FLY) […]
Sodium Reduction Program Incorporating Genetic Profile and an AI-Based App: A Randomized Clinical Trial
JAMA Netw Open. 2025 Oct 1;8(10):e2537540. doi: 10.1001/jamanetworkopen.2025.37540. ABSTRACT IMPORTANCE: Excess salt intake is a major modifiable risk factor for hypertension and cardiovascular disease. Personalized interventions using genetic information and digital tools, such as smartphone applications, may enhance sodium reduction, but evidence remains limited. OBJECTIVE: To evaluate the effectiveness of a sodium reduction program incorporating […]
Smartphone-Based Muscle Relaxation for Migraine in the Emergency Department: A Randomized Clinical Trial
JAMA Netw Open. 2025 Oct 1;8(10):e2534221. doi: 10.1001/jamanetworkopen.2025.34221. ABSTRACT IMPORTANCE: The emergency department (ED) is a critical point of contact within the health care system and an opportunity to initiate nonpharmacologic migraine treatment. OBJECTIVE: To examine whether progressive muscle relaxation (PMR) smartphone-based migraine self-management improved patient-reported outcomes for migraine compared with enhanced usual care. DESIGN, […]
Testing the ELSA Birth App During Pregnancy and Labor for Primiparous Women: Randomized Controlled Trial
J Med Internet Res. 2025 Oct 16;27:e72807. doi: 10.2196/72807. ABSTRACT BACKGROUND: Early labor is often managed at home without professional support. The Birth App (Birth by Heart) is an app designed to support women during early labor. A pilot study revealed that women found the app’s exercises simple, understandable, and practical. The app was perceived […]
A pilot study of remote cognitive assessment in children using the NIH toolbox participant/examiner app
Sci Rep. 2025 Oct 16;15(1):36204. doi: 10.1038/s41598-025-20256-7. ABSTRACT The demand for remote assessment tools has increased, yet there is a lack of standardized adaptations for remote administration. This pilot study investigates the equivalency of in-person and remote cognitive assessments using the NIH Toolbox Cognition Battery (NIHTB-CB) among children aged 7 to 17 years. Forty-seven children […]
Strategies employed by Iranian nurses for managing workplace bullying: a qualitative descriptive study
BMJ Open. 2025 Oct 16;15(10):e094833. doi: 10.1136/bmjopen-2024-094833. ABSTRACT OBJECTIVES: This study aimed to explore the strategies employed by nurses to manage workplace bullying. DESIGN: Qualitative descriptive study. SETTING: The study was conducted in a hospital located in western Iran between 21 March and 22 September 2023. PARTICIPANTS: A purposive sample of 14 nurses was selected. […]
A Precision Model for Evaluating HLA-Associated Risk in Drug-Induced Liver Injury

Modeling adaptive immune reactions in vitro is a significant gap in liver research and drug development. Immune-mediated liver injuries like drug hypersensitivity, autoimmune hepatitis, and immune-related adverse effects from cancer immunotherapy are caused by complicated and patient-specific mechanisms. Current preclinical processes cannot be reproduced. Idiosyncratic drug-induced liver injury (iDILI) represents a major clinical and regulatory […]
Silent Selection: Environmental Impact of Non-Antibiotic Drugs on Aquatic Antibiotic Resistance
Antimicrobial resistance (AMR) accounts for nearly 9% of global deaths and represents a growing public health threat worldwide. Due to the insufficiency in the development and commercialization of new antibiotics, researchers have turned to the possibility of using antibiotic and non-antibiotic drug combinations as an alternative approach to the management of resistant infections. Beta blockers, […]
Maldives Achieves First-Ever Triple Elimination of Mother-to-Child Transmission of HIV, Syphilis, and Hepatitis B

The World Health Organization (WHO) has officially certified the Maldives for eliminating mother-to-child transmission (EMTCT) of hepatitis B, building on its previous 2019 certification for the elimination of HIV and syphilis. This remarkable accomplishment makes the Maldives the first country in the world to achieve “triple elimination,” marking an extraordinary milestone in maternal and child health. […]
Microplastic Exposure from Plastic Tableware and Its Impact on Sperm Quality: Elucidating the FOXA1–MAP3K1/p38 Mechanistic Pathway

Microplastics (MPs), which are plastic particles smaller than 5 mm, are ubiquitous environmental contaminants found in air, soil, water, and food chains. More evidence suggests that MPs are capable of bioaccumulation in human tissue, increasing the concern about their potential toxicological and reproductive effects. It is critical to investigate the environmental factors that contribute to […]






